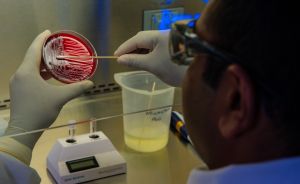

Professora Conceição Calhau lidera investigação que vai tentar estudar o papel das bactérias intestinais e da vitamina D na resposta imunitária à Covid-19
SIC Notícias | Diário de Notícias

Análise à Covid-19 nos EUA e a estratégia para a imigração de Donald Trump, com os comentários de Tiago Moreira de Sá, Professor da NOVA FCSH
TVI24 [min 45:00]
Photo by Charles Deluvio on Unsplash

Análise de Carla Nunes, Diretora da ENSP-NOVA, à curva epidemiológica da DGS e pico da pandemia no Jornal das 8 da TVI
TVI [51:48]
Photo by Agence Olloweb on Unsplash